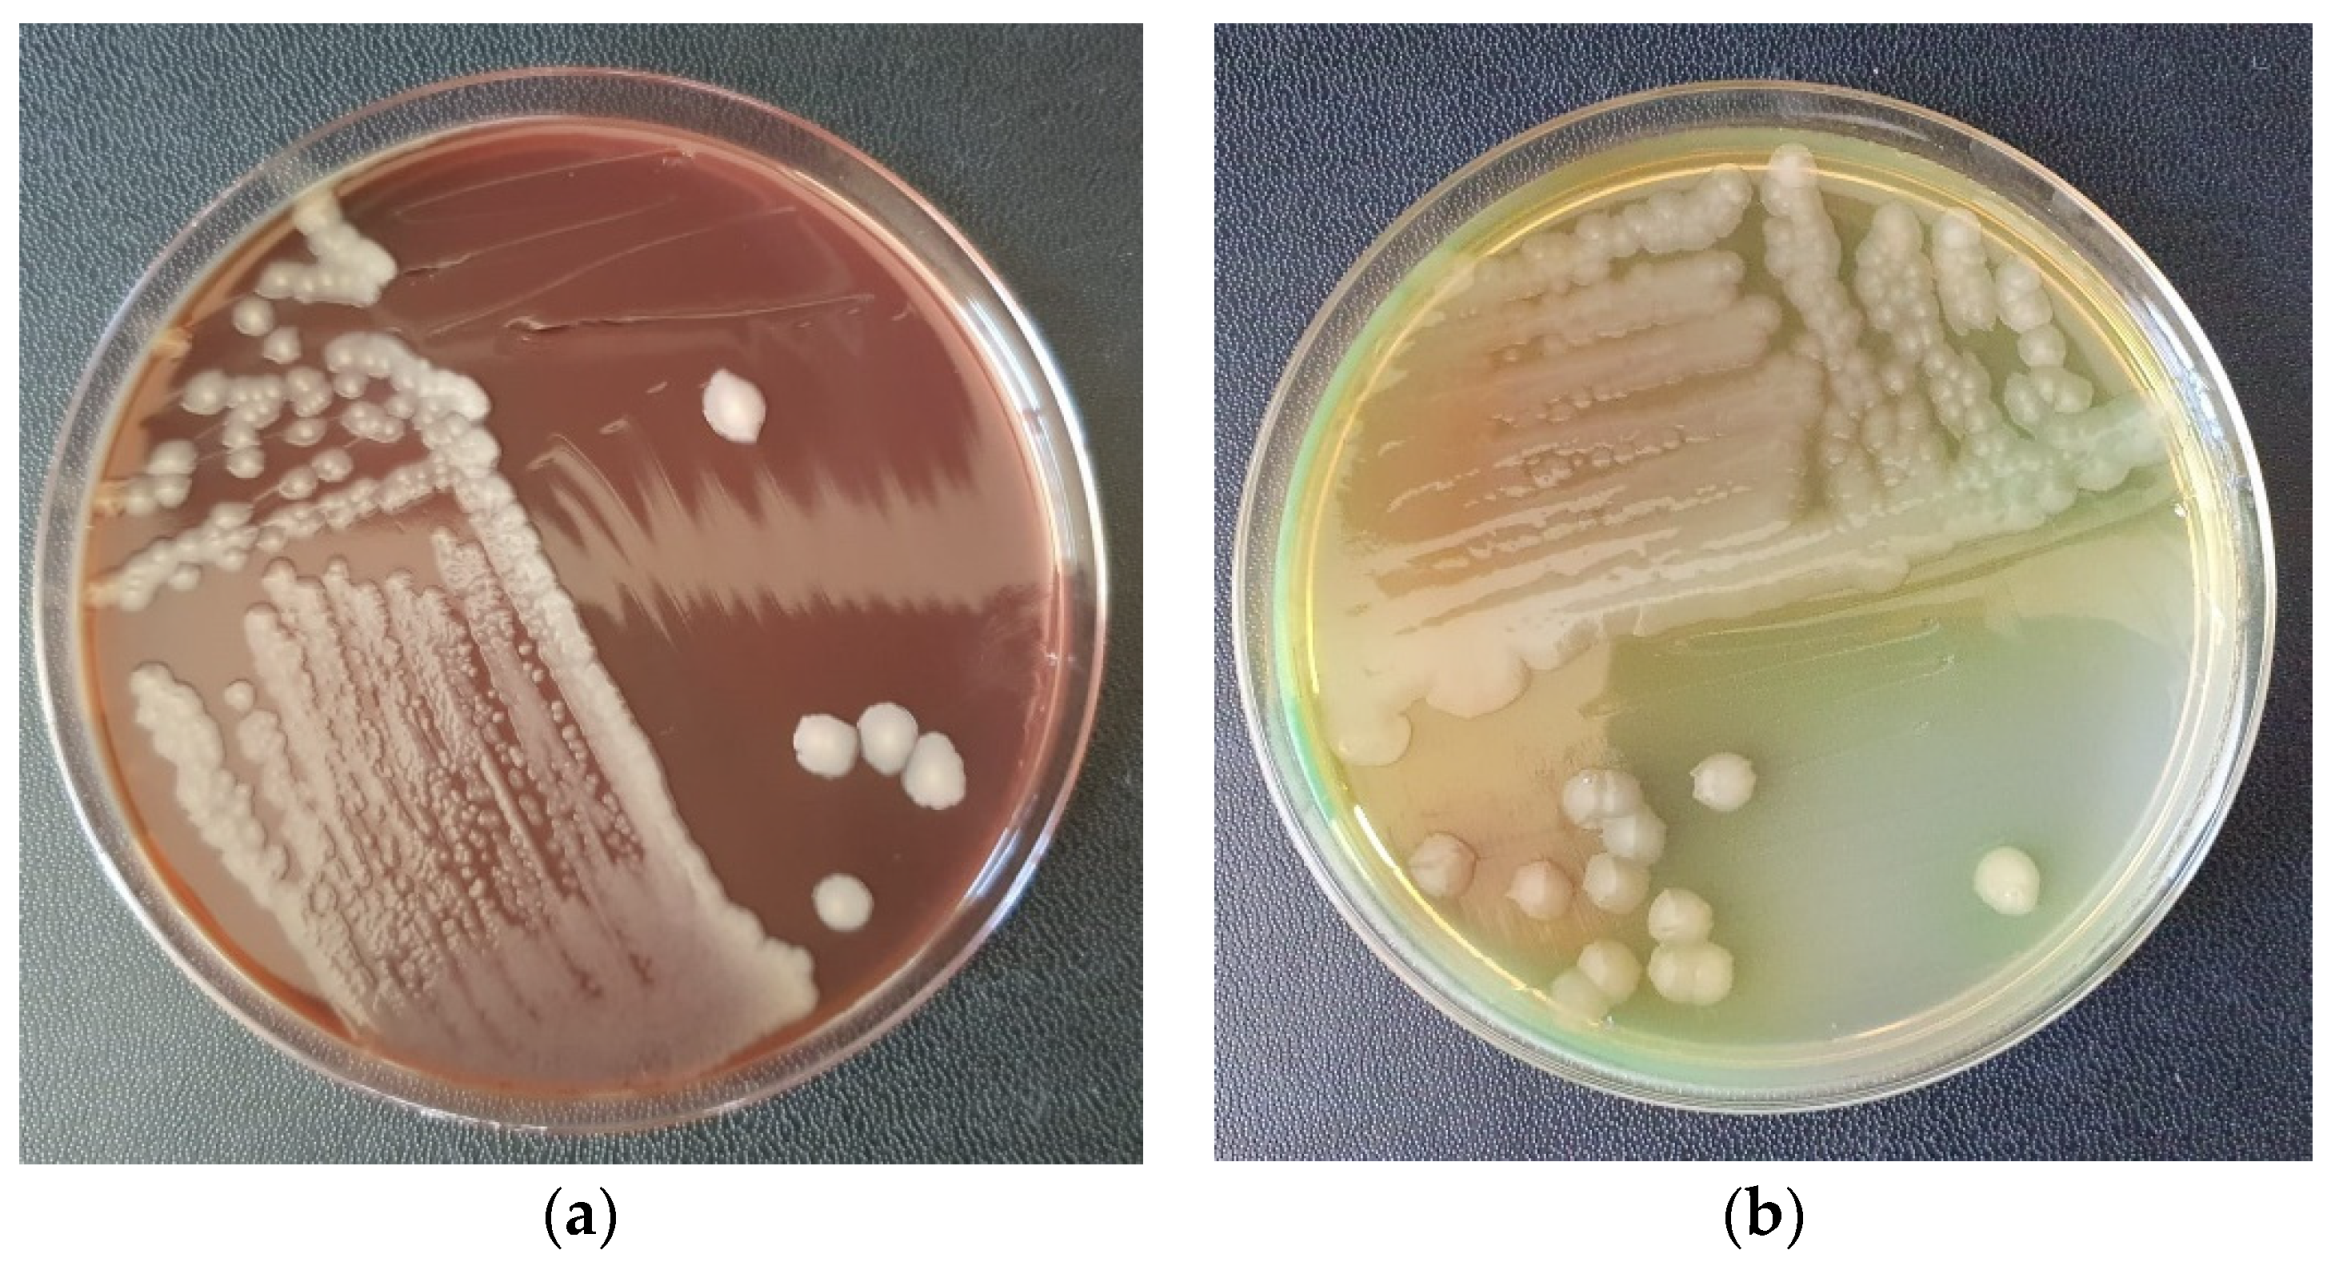
Vetsci 10 00642 g003

The Bacteriophages Therapy of Interdigital Pyoderma Complicated by Cellulitis with Antibiotic-Resistant Pseudomonas aeruginosa in a Dog—Case Report
Abstract
:Simple Summary
Abstract
1. Introduction
2. Case Report
- After the clinical examination, venous blood was collected and laboratory tests were performed, which included: blood count, C-reactive protein, fibrinogen, acute phase reactants (ESR), creatine phosphokinase (CPK), urea, creatinine, urine analysis, blood gas, electrolytes and glucose analysis. Cytological exam of the purulent exudate was made to rule out neoplasia, fungal and parasitical infection.
- Imaging investigations were carried out with computed tomography (CT), to highlight the presence of subcutaneous air that frequently occurs in the case of infections, but also to observe areas of muscle necrosis and to reveal a possible foreign body.
- Drain incisions were made in order to eliminate the liquid from the edema level (Figure 2) and samples were taken from the liquid for bacteriological cultures, as well as samples of tissue fragments from the necrotic area. The work steps were performed according to conventional methods of clinical microbial analysis. The samples were plated on regular culture media (Mueller Hinton blood agar, Oxoid) and incubated at 37 °C. After 24 h, the cultural, morphological and biochemical aspects of the bacterial strains that grew on the surface of the culture medium were examined.
- 4.
- An antibiogram was performed in order to determine the use of systemic antibiotics. Strains isolated from the pure culture were tested against different panels of antibiotics. Antimicrobial susceptibility testing of the isolated strains was performed using the Kirby-Bauer disk diffusion method according to international standards (EUCAST, 2023). The evaluation of the results was based on the diameter of the inhibition zones determined by the antibiotics: Norfloxacin (10 µg), Doxycycline (30 µg), Enrofloxacin (30 µg), Ampicillin (10 µg), Amoxicillin-Clavulanic Acid (10 µg), Neomycin (30 µg), Ceftiofur (30 µg), Ceftriaxone (30 µg, Oxoid). Based on the results obtained, the strains were classified as “S” susceptible and “R” resistant [12].
- 5.
- The dog was subjected to supportive therapy with infusion solutions of sodium chloride, Ringer and glucose 5%.
- 6.
- The necrotic area was periodically cleaned and disinfected with hypochlorous acid (HOCl), a potent antibacterial and antiviral agent [13], for two days, until the results of bacteriological examination and antibiogram were obtained. After delimiting the necrotic areas, the bacteriophage treatment was initiated according to the manufacturer’s instructions. The commercial suspension used in therapy contains a mixture of sterile purified phagolyzed filtrates from 6 types of microorganisms (Piobacteriophage Polyvalent Polyphage—Sixtaphages, MIKROGEN, Russia) and contains bacteriophages for Staphylococcus spp., Streptococcus spp., Proteus vulgaris, Proteus mirabilis, Pseudomonas aeruginosa and enteropathogenic Escherichia coli.
- 7.
- For each application, 40 mL of bacteriophage suspension was used in the form of swabs on the injured surface, and the therapy was applied intermittently for a period of 3 months. The bacteriophage suspension was administered 2 times/day, at 12-h intervals for a period of 20 days. After this period, the suspension was administered once a day for 10 days. Bacteriophages were then applied every three days, for 60 days (as a preventive measure against microbial reinfection), until complete healing of the lesion of the affected limb was obtained. After using bacteriophages and leaving the treated area for a few minutes, a bandage impregnated with neutral ointment and paraffin (Grassolind®, Hartmann) was applied, in order to stimulate the formation of granulation tissue, epithelization, and prevent adhesion of the wound’s bandage.
3. Discussion
4. Conclusions
Author Contributions
Funding
Institutional Review Board Statement
Informed Consent Statement
Data Availability Statement
Acknowledgments
Conflicts of Interest
References
- Nielsen, S.S.; Bicout, D.J.; Calistri, P.; Canali, E.; Drewe, J.A.; Garin-Bastuji, B.; Gonzales Rojas, J.L.; Gortázar, C.; Herskin, M.; Michel, V.; et al. Assessment of listing and categorisation of animal diseases within the framework of the Animal Health Law (Regulation (EU) No 2016/429): Antimicrobial-resistant Pseudomonas aeruginosa in dogs and cats. EFSA J. 2022, 20, 7310. [Google Scholar] [CrossRef]
- Dec, M.; Wernicki, A.; Urban-Chmiel, R. Efficacy of experimental phage therapies in livestock. Anim. Health Res. Rev. 2020, 21, 69–83. [Google Scholar] [CrossRef] [PubMed]
- Kropinski, A.M. Phage Therapy—Everything Old is New Again. Can. J. Infect. Dis. Med. Microbiol. 2006, 17, 297–306. [Google Scholar] [CrossRef] [PubMed]
- Samson, J.E.; Magadán, A.H.; Sabri, M.; Moineau, S. Revenge of the phages: Defeating bacterial defences. Nat. Rev. Microbiol. 2013, 11, 675–687. [Google Scholar] [CrossRef] [PubMed]
- Beschastnov, V.V.; Egorikhina, M.N.; Tulupov, A.A.; Pogodin, I.E.; Orlinskaya, N.Y.; Antoshina, V.V.; Shirokova, I.Y.; Ryabkov, M.G. Immobilization of Bacteriophages in Ex Tempore Hydrogel for the Treatment of Burn Wound Infection. Gels 2023, 9, 625. [Google Scholar] [CrossRef] [PubMed]
- Loponte, R.; Pagnini, U.; Iovane, G.; Pisanelli, G. Phage Therapy in Veterinary Medicine. Antibiotics 2021, 10, 421. [Google Scholar] [CrossRef] [PubMed]
- Batinovic, S.; Wassef, F.; Knowler, S.A.; Rice, D.T.F.; Stanton, C.R.; Rose, J.; Tucci, J.; Nittami, T.; Vinh, A.; Drummond, G.R.; et al. Bacteriophages in Natural and Artificial Environments. Pathogens 2019, 8, 100. [Google Scholar] [CrossRef]
- Gamachu, S.B.; Debalo, M. Review of bacteriophage and its applications. Int. J. Vet. Sci. Res. 2022, 8, 133–147. [Google Scholar] [CrossRef]
- Burrowes, B.; Harper, D.R.; Anderson, J.; McConville, M.; Enright, M.C. Bacteriophage Therapy: Potential uses in the control of antibiotic-resistant pathogens. Expert. Rev. Anti-Infect. Ther. 2011, 9, 775–785. [Google Scholar] [CrossRef]
- Moodley, A.; Kot, W.; Nälgård, S.; Jakociune, D.; Neve, H.; Hansen, L.H.; Guardabassi, L.; Vogensen, F.K. Isolation and characterization of bacteriophages active against methicillin-resistant Staphylococcus pseudintermedius. Res. Vet. Sci. 2019, 122, 81–85. [Google Scholar] [CrossRef]
- Squires, R. Bacteriophage Therapy for Management of Bacterial Infections in Veterinary Practice: What Was Once Old Is New Again. N. Z. Vet. J. 2018, 66, 229–235. [Google Scholar] [CrossRef]
- EUCAST. Antimicrobial Susceptibility Testing EUCAST Disk Diffusion Method, Version 11 (January 2023). Available online: https://www.eucast.org/fileadmin/src/media/PDFs/EUCAST_files/Disk_test_documents/2023_manuals/Manual_v_11.0_EUCAST_Disk_Test_2023.pdf (accessed on 1 February 2023).
- Hatanaka, N.; Yasugi, M.; Sato, T.; Mukamoto, M.; Yamasaki, S. Hypochlorous acid solution is a potent antiviral agent against SARS-CoV-2. J. Appl. Microbiol. 2022, 132, 1496–1502. [Google Scholar] [CrossRef]
- Miller, W.H.; Griffin, C.E.; Campbell, K.L. Muller & Kirk’s Small Animal Dermatology; Elsevier Mosby: St. Louis, MI, USA, 2013; pp. 184–222. ISBN 978-1-4160-0028-0. [Google Scholar]
- Loeffler, A.; Linek, M.; Moodley, A.; Guardabassi, L.; Sung, J.M.L.; Winkler, M.; Weiss, R.; Lloyd, D.H. First report of multiresistant, mecA-positive Staphylococcus intermedius in Europe: 12 cases from a veterinary dermatology referral clinic in Germany. Vet. Dermatol. 2007, 18, 412–421. [Google Scholar] [CrossRef]
- Ventrella, G.; Moodley, A.; Grandolfo, E.; Parisi, A.; Corrente, M.; Buonavoglia, D.; Guardabassi, L. Frequency, antimicrobial susceptibility and clonal distribution of methicillin-resistant Staphylococcus pseudintermedius in canine clinical samples submitted to a veterinary diagnostic laboratory in Italy: A 3-year retrospective investigation. Vet. Microbiol 2017, 211, 103–106. [Google Scholar] [CrossRef] [PubMed]
- Hritcu, O.M.; Schmidt, V.M.; Salem, S.E.; Maciuca, I.E.; Moraru, R.F.; Lipovan, I.; Mareș, M.; Solcan, G.; Timofte, D. Geographical Variations in Virulence Factors and Antimicrobial Resistance Amongst Staphylococci Isolated from Dogs From the United Kingdom and Romania. Front. Vet. Sci. 2020, 7, 414. [Google Scholar] [CrossRef]
- Drenkard, E. Antimicrobial resistance of Pseudomonas aeruginosa biofilms. Microbes Infect. 2003, 5, 1213–1219. [Google Scholar] [CrossRef]
- Harada, K.; Arima, S.; Niina, A.; Kataoka, Y.; Takahashi, T. Characterization of Pseudomonas aeruginosa isolates from dogs and cats in Japan: Current status of antimicrobial resistance and prevailing resistance mechanisms. Microbiol. Immunol. 2012, 56, 123–127. [Google Scholar] [CrossRef]
- Poole, K. Pseudomonas aeruginosa: Resistance to the max. Front. Microbiol. 2011, 2, 65. [Google Scholar] [CrossRef] [PubMed]
- Ferriol-González, C.; Domingo-Calap, P. Phage Therapy in Livestock and Companion Animals. Antibiotics 2021, 10, 559. [Google Scholar] [CrossRef] [PubMed]
- Hawkins, C.; Harper, D.; Burch, D.; Anggård, E.; Soothill, J. Topical treatment of Pseudomonas aeruginosa otitis of dogs with a bacteriophage mixture: A before/after clinical trial. Vet. Microbiol. 2010, 146, 309–313. [Google Scholar] [CrossRef]
- Furusawa, T.; Iwano, H.; Higuchi, H.; Yokota, H.; Usui, M.; Iwasaki, T.; Tamura, Y. Bacteriophage can lyse antibiotic-resistant Pseudomonas aeruginosa isolated from canine diseases. J. Vet. Med. Sci. 2016, 78, 1035–1038. [Google Scholar] [CrossRef] [PubMed]
- Wright, A.; Hawkins, C.H.; Anggard, E.E.; Harper, D.R. A controlled clinical trial of a therapeutic bacteriophage preparation in chronic otitis due to antibiotic-resistant Pseudomonas aeruginosa; a preliminary report of efficacy. Clin. Otolaryngol. 2009, 34, 349–357. [Google Scholar] [CrossRef] [PubMed]
- Ferriol-González, C.; Domingo-Calap, P. Phages for Biofilm Removal. Antibiotics 2020, 9, 268. [Google Scholar] [CrossRef] [PubMed]
- Pires, D.P.; Melo, L.; Vilas Boas, D.; Sillankorva, S.; Azeredo, J. Phage therapy as an alternative or complementary strategy to prevent and control biofilm-related infections. Curr. Opin. Microbiol. 2017, 39, 48–56. [Google Scholar] [CrossRef] [PubMed]
- Bondy-Denomy, J.; Pawluk, A.; Maxwell, K.; Davidson, A.R. Bacteriophage genes that inactivate the CRISPR/Cas bacterial immune system. Nature 2013, 493, 429–432. [Google Scholar] [CrossRef]

Disclaimer/Publisher’s Note: The statements, opinions and data contained in all publications are solely those of the individual author(s) and contributor(s) and not of MDPI and/or the editor(s). MDPI and/or the editor(s) disclaim responsibility for any injury to people or property resulting from any ideas, methods, instructions or products referred to in the content. |
© 2023 by the authors. Licensee MDPI, Basel, Switzerland. This article is an open access article distributed under the terms and conditions of the Creative Commons Attribution (CC BY) license (https://creativecommons.org/licenses/by/4.0/).
Share and Cite
Grecu, M.; Henea, M.-E.; Rîmbu, C.M.; Simion, C.; Şindilar, E.-V.; Solcan, G. The Bacteriophages Therapy of Interdigital Pyoderma Complicated by Cellulitis with Antibiotic-Resistant Pseudomonas aeruginosa in a Dog—Case Report. Vet. Sci. 2023, 10, 642. https://doi.org/10.3390/vetsci10110642
Grecu M, Henea M-E, Rîmbu CM, Simion C, Şindilar E-V, Solcan G. The Bacteriophages Therapy of Interdigital Pyoderma Complicated by Cellulitis with Antibiotic-Resistant Pseudomonas aeruginosa in a Dog—Case Report. Veterinary Sciences. 2023; 10(11):642. https://doi.org/10.3390/vetsci10110642
Chicago/Turabian StyleGrecu, Mariana, Mădălina-Elena Henea, Cristina Mihaela Rîmbu, Cătălina Simion, Eusebiu-Viorel Şindilar, and Gheorghe Solcan. 2023. "The Bacteriophages Therapy of Interdigital Pyoderma Complicated by Cellulitis with Antibiotic-Resistant Pseudomonas aeruginosa in a Dog—Case Report" Veterinary Sciences 10, no. 11: 642. https://doi.org/10.3390/vetsci10110642
APA StyleGrecu, M., Henea, M.-E., Rîmbu, C. M., Simion, C., Şindilar, E.-V., & Solcan, G. (2023). The Bacteriophages Therapy of Interdigital Pyoderma Complicated by Cellulitis with Antibiotic-Resistant Pseudomonas aeruginosa in a Dog—Case Report. Veterinary Sciences, 10(11), 642. https://doi.org/10.3390/vetsci10110642

